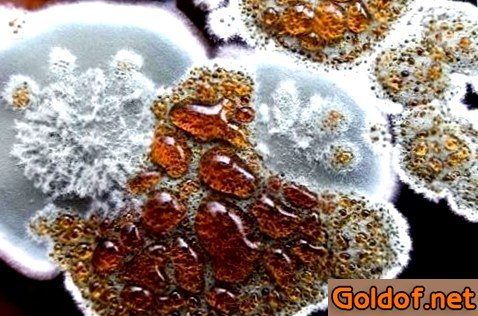

Обработка стенок от плесени

Не обращая внимания на то, что один из переходных шагов в развитии медицины связан с открытием плесени, она так и не стала «народной любимицей».
Вероятнее, это связано с повсеместным распространением всесущего грибка и его свойством, не только портить строй и материалы отделки, да и оказывать болезнетворное действие на человеческий организм, а в особенности людей со сниженным иммунитетом, что может стать обстоятельством серьезных последствий. Как мы знаем, излишняя влажность в помещении может стать обстоятельством возникновения плесени и грибка, какие не только портят внешний вид стенок, да и вредят здоровью.
Обычно люди мучаются от не поддающейся объяснению аллергии, астмы и большого количества других заболеваний желудочно-кишечного тракта и дыхательной системы. Опытные специалисты, при обнаружении у вас таких заболеваний, советуют, сперва, направить внимание на состояние стенок у вас в квартире или доме и при обнаружении плесени без промедлений начать мероприятия по борьбе с ней. Эффективная борьба с плесенью не представляется возможной без теоретических познаний о ней и критериях ее подходящего развития. С био точки зрения, плесень представляет собой микроскопичный грибок, который сам по для себя не представляет угрозы для человека. Громаднейший вред для человека он несет в момент размножения, в то время, когда его споры начинают выделять токсин, вызывающий аллергические реакции. Многие неопытные мастера, впервой столкнувшись с плесенью в квартире, задаются вопросом: «Как удалить грибок со стену быстро и более результативно?», и данный вопрос очень животрепещущ, так как, согласно точки зрения профессионалов, единственно надёжный метод сохранить помещение от негативного деяния плесени, есть ее удаление. В настоящей статье мы докажем для вас это.
Плесень: а вы осознаете неприятеля в лицо?
Вы впервой замечаете изменение цвета поверхностей, например, позеленение или посинение? Отыскали тёмные хлопья у потолка или шелушение стенок? Столкнулись с появлением корочек или рыхловатого пылеобразного налета на продуктах? Знакомьтесь, ваш неприятель – плесень.
Грибок или плесень – это используемое в быту наименование плесневых грибов, отличительной изюминкой которых есть развитый мицелий (грибница), проникающий вглубь питательной среды, называемой субстратом. Также, плесневые грибы имеют еле приметные плодоносящие тела, располагающиеся на поверхности субстрата. Их мы почти всегда лицезреем и именуем плесенью. Они не могут к воспроизводству питательных веществ и только поглощают готовые, выделяя в вохдух углекислый газ, эфирные масла и токсические продукты собственной жизнедеятельности. Позже рассмотрим главные разновидности плесневых грибков.

Разновидности плесневых грибков: короткая характеристика
Все имеющиеся плесневые грибки, с которыми может столкнуться начинающий или опытный мастер в сфере строительства, можно поделить на три подвида:
Плесневые грибки или традиционная плесень – более распространенный подвид плесневых грибов, с которым можно столкнуться в быту. Они вырастают на бетоне, камнях, обоях также лакокрасочных материалах. В исходный период собственного развития они являются зеленоватые, голубые, бурые или тёмные точки, какие позже разрастаются, образуя пятна значимых размеров. При долгом действии плесневых грибков на стройматериал, они сумеют стать обстоятельством его разрушения практически на всю глубину;

Грибок синевы, который в процессе собственного роста и жизнедеятельности поражает клетчатку деревянной породы. Отличить его от других разновидностей можно по неприглядным серо-синим пятнам, образующимся на поверхности деревянной породы. Синева, попадая через пленку лакокрасочных материалов, образует в деревянной породе необыкновенные ходы или водопроводы, по которым вода попадает внутрь деревянной породы, и тем возрастает ее влажность. А повышенная влажность, как мы знаем, подходящее условие для развития плесени. Более достаточно нередко в такой замкнутый круг грибкового поражения попадает сосна;

Грибки тления поражают только деревянную породу. Различают белоснежную, бурую и бактериальную гнилость. Бактериальная гнилость разъедает изнутри деревянную породу, что способствует внутреннему разложению целлюлозы. Вместе с этим материал теряет свои прочностные свойства, темнеет или сереет. При поражении деревянной породы белоснежной гнилостью она практически не меняет собственный цвет, так как гнилость разрушает не только деревянную породу, да и лигнин, входящий в ее состав. Еще одна разновидность грибков тления – бурая гнилость, можно как сухой, так и влажной. При поражении последней, на деревянной породе неторопливо начинают появляться полосы и пятна желтоватого, кофейного и темного цветов, на месте которых позже возникают трещины. При поражении деревянной породы сухой гнилостью пораженные участки приобретают карий цвет, сжимаются, по окончании чего происходит их раскалывание вдоль и поперек волокон;

Более ужасным противником для человека и его жилья есть белоснежный домовой гриб. Чтобы вы смогли оценить масштабы его угрозы, напомним, что в месяц, боровик может всецело поразить пол из дубовых досок шириной 40 мм. Исходя из этого в древности, чтобы не допустить распространение грибка, дома, пораженные деревянной породой, сжигали;

Не считая вышеперечисленных грибковых микробов, есть еще одна разновидность микробов, рука об руку идущих с традиционным грибком. Речь входит о высолах, поражающих цементные, кирпичные, заштукатуренные или облицованные мрамором фасады. Они являются щелочной или соляной налет, образующийся на обозначенных поверхностях в сухую погоду, в составе которых обнаруживаются нерастворимые соли серной кислоты, карбонаты или силикаты.

Главные происшествия возникновения грибка и плесени на стенках
Основополагающая событие возникновения плесени – излишняя влага, которая появляется не только в помещениях, да и в строй перегородках, что обосновано ошибками, допущенными в процессе укладки изоляции горизонтальных и вертикальных фундаментов. Кроме этого, обстоятельством влажности могут быть неисправности в системах вентиляции. Феномен содержится в том, что производители позиционируют пластмассовые окна как систему высокой плотности, но они сумеют только ухудшить проблемы, связанные с неэффективной вентиляцией и микроклиматом помещения. 2-ая событие происхождения грибка – вымерзание стенок.
Плесень и грибок сумеют распространяться на поверхности не только деревянных, да и кирпичных стенок, вместе с этим во 2-м случае масштабы проблемы не так беспредельны, так как чтобы от нее избавиться, довольно грибок с поверхности стены. В случае поражения деревянной породы единственно верным средством от плесени на стенках есть удаление пораженного участка деревянной породы и его сжигание. В связи с тем, что темпы размножения грибка высочайшие, и за год он может поразить деревянную породу на 70 %, он страшен не только для поверхностей и конструктивных частей строения, да и для мебели.

Важно! Чтобы провести результативную борьбу с грибком и правильно ответить на вопрос: «Как избавиться от плесени на стенках?», необходимо знать событие ее возникновения, что разрешит подобрать комплекс действующих мероприятий по борьбе с ней и веровать в их надежности и долговечности.
Главные причины, способствующие формированию грибка:
Вымерзание внешних стенок – в случае если по бокам и в углах стенок вы отыскали чёрный налет, вы имеете возможность быть убеждены, что событие его возникновения – вымерзание стенок. Чтобы убрать плесень на стенках, необходимо их просушить и проверить сцепление штукатурки;
Влага, идущая из грунта, в присутствии которой можно удостовериться, обнаружив потеки в местах соединения пола нижнего этажа или подвала и стенок. В данном случае необходимо удостовериться в эффективности горизонтальной изоляции фундаментных стенок. В случае ее повреждения необходимо выполнить ее ремонт, заранее просушив стены. В случае если пол не считая этого оказался влажным, вероятнее ремонт изоляции не получится произвести, не удалив фундамент;
Неисправность водопроводной канализации, о которой может свидетельствовать возникновение воды вдоль водопроводных труб. Еще одним знаком неисправности водопроводной канализации могут быть влажные следы на стенке на высоте края ванны рядом от ванной комнаты. Почти всегда, осушение оказывает помощь решить проблему, но в случае запоздалого обнаружения обозначенных сигналов может привести к чрезмерному распространению грибка и неосуществимости его быстрого поражения;

Протекающий водосток и желоба, почти всегда, можно отыскать только снаружи, в случае возникновения потеков на штукатурке. В дождливую погоду, в то время, когда влага превосходит максимально допустимые нормы, потеки сумеют появляться и в центре. Обычно неопытные мастера не придают данной дилемме особого значения, считая ее само собой разумеющейся,, пока она не достигнет определенных масштабов. Но, утечки, покинутые без присмотра, сумеют сделать реальную проблему только зимний период, в то время, когда случится вымерзание воды в штукатурке;
Неисправность вентиляционных систем ванной комнаты или кухни – еще одна событие происхождения плесени на стенках, так как обозначенные помещения характеризуются относительно высокой влажностью воздуха, что способствует резвую формированию грибка. Что касается мест, более подверженных возникновению грибка, то к ним относятся не отлично вентилируемые места, а именно, углы стенок. В громаднейшей степени это относится и новостроек, в каких стены еще довольно плотные. В данном случае повышенное внимание необходимо выделить проветриванию комнат или установить систему кондиционирования.

Перед тем как ответить на вопрос: «Как убрать плесень на стенках?», подведем результат произнесенному выше и выделим главные происшествия образования грибка:
- Применение стройматериалов, характеризующихся огромным уровнем остаточной влажности;
- Неэффективная гидроизоляция междупанельных швов;
- Плохая гидроизоляция фундаментов;
- Чрезвычайно высокая плотность помещений, в каких установлены пластмассовые окна и не хватает эффективная естественная вентиляция помещений;
- Нарушенный отопительный баланс квартиры, проявляющийся в виде неравномерного прогрева помещений при высокой влажности снаружи;
- Происхождение недочетов кровли и намокание стенок при косых дождиках;
- Переизбыток комнатных растений, частые стирки, сочетающиеся с недостающим проветриванием.

Профилактические мероприятия и устранение событий возникновения грибка
До того как приступить к обработке стенок от плесени, необходимо разобраться в обстоятельствах ее происхождения, какие мы разглядели выше. В связи с тем, что грибок возникает во влажных помещениях с недостаточной вентиляцией, профилактические мероприятия ориентированы на выравнивание температуры и влажности, зачем по окончании кропотливого просушивания необходимо отрешиться от плотного закрывания дверей. При недостаточной вентиляции помещения в канале вентиляции устанавливают вентилятор.

Обработка стенок от грибка и плесени: пошаговое управление
Обычно грибок поражает слой штукатурки, который позже подлежит обработке. Но перед тем, как приступить к обработке стенок от грибка и плесени, необходимо проверить сцепление штукатурного слоя с поверхностью стены. Для этого по всей поверхности стены необходимо постучать молотком. В случае возникновения глухого звука, вы имеете возможность быть уверенны, что штукатурка испортилась и отделилась от стены. Из этого делаем вывод, что она подлежит удалению с следующей подменой. В случае если сцепление штукатурки с поверхностью стены есть надежным, поверхность стены необходимо обработать спец антисептиком для стенок от плесени. Вместе с этим необходимо правильно следовать аннотации, предлагаемой производителем дезинфицирующего продукта.

До работы, поверхность обрабатываемой стены необходимо основательно омочить водой, чтобы не допустить распространение спор грибка в помещения. Применяя металлическую щетку или шпатель, очистите пораженное место от плесени и других видов грибка, всецело удалив вместе с этим рыхловатый слой штукатурки. Чтобы повысить эффективность данного мероприятия, обработайте цементные стены особенным очистительным веществом, способствующим открытию пор цементного раствора.

Важно! В процессе удаления грибка необходимо использовать особенные средства защиты — маски, респираторы и перчатки, и обеспечить результативную вентиляцию помещения, так как вдыхание частичек плесени и спор грибка грозит ужасными последствиями для здоровья. Кроме этого, обеспечив нужные условия, вы предупредите распространение грибка на непораженных участках. Если вы планируете эксплуатировать помещение сходу после обработки, вы должны знать, что она должна осуществляться по окончании 40 восемь часов по окончании окончания работ.

Осуществив удаление пораженных участков, необходимо спалить инфицированные куски штукатурки.
Позже необходимо произвести обработку чистой поверхности особенным дезинфицирующим веществом. По окончании подготовительного разведения раствора водой нанесите раствор на пораженный участок стены с припасом в один метр с каждой стороны, чтобы точно не допустить зарождающиеся колонии. Для нанесения дезинфицирующего состава применяйте валик, кисть или пистолет-распылитель.
Важно! Производители предлагают направить внимание на фунгициды (противогрибковые препараты), реализующиеся в виде спреев в особенных баллончиках-распылителях. В связи с тем, что в данном случае количество спрея будет небольшим (около 0,5 л.), данное решение подойдет для помещений с маленькой площадью. Данный состав наносят в два или три слоя, вместе с этим любой следующий слой наносится по окончании подсыхания прошедшего.

Позже реализовывают грунтовку стенок грунтовочным составом глубочайшего проникания, владеющим дезинфицирующими или фунгицидными качествами. По окончании того, как поверхность всецело высохнет, необходимо повторно нанести грунтовочный состав. В заключение делают шпаклевку, штукатурку и финальную отделку стенок.
Если вы столкнулись с сильно запущенным случаем, и грибок развился так, что успел просочиться в глубочайшие слои материалов отделки (в особенности пористых) с формированием в их грибницы, ее необходимо всецело удалять, из чего можно прийти к выводу, что внешняя обработка не принесет подабающих результатов, а только на время скроет наружные следы поражения. В данном случае, если вы имеете возможность всецело заменить пораженный кусок материалов отделки, не третируйте этим и последуйте совету профессионалов.

Чем обработать стены от плесени? Выбор действующего антисептика
Рынок может предложить много препаратов, результативно борющихся с плесенью и грибком на стенках, и чтобы сделать верный выбор, необходимо основательно изучить сопроводительную аннотацию к продукту и проконсультироваться с торговцем. Это обосновано тем, что препараты, результативно ликвидирующие один вид грибка, могут быть не результативны в борьбе с другой разновидностью данного мельчайшего организма. Но, есть и универсальные препараты, какие смогут употребляться как в помещения, так и для обработки фасадов построек. На рынке вы имеете возможность увидеть составы, реализующиеся в готовом виде, и сухие консистенции, нуждающиеся в разведении. В качестве растворителя сумеют употребляться уайт-спирит, вода или скипидар. Рассмотрим более распространенные дезинфицирующие и фунгицидные составы:
- Atlas Mykos – средство, созданное для борьбе не только с плесенью, да и лишайниками, мхом или водными растениями. Оно продается в виде концентрата и может употребляться в случайных помещениях с завышенной влажностью, и для обработки фасадов построек. Перед применением его разводят водой в соотношении 1:2, а в случае обработки минеральных поверхностей данное соотношение создает 1:5;
- Spectrum Фунгицид – средство, результативно уничтожающее грибок на деревянных, заштукатуренных и обработанных лакокрасочными материалами поверхностях. Может употребляться как снаружи, так и в помещений, подверженных завышенной влажности;
- Ксиолат – эффективное средство, разрушающее структуру плесени и на молекулярном уровне поникающее в междумолекулярную структуру хоть какого стройматериала, например, дерева, кирпича, бетона и других;
- Тефлекс – превосходный продукт, удаляющий плесень и грибок, характеризующийся экологической безопасностью и долговечностью, в связи с чем, есть надёжным для человека и животных;
- FILASMUFFY – средство, продающееся в виде спрея и результативно удаляющее плесень с поверхности обоев, штукатурки, бетона или кирпича;
- Снежка Пропитка – есть действующим противогрибковым средством, удаляющим не только плесень и грибок, да и водные растения, лишайники и мхи с поверхности кирпичной кладки, штукатурки и лакокрасочных покрытий. Употребляется как снаружи, так и в помещения.

Традиционные средства, действующие при борьбе с плесенью
С давних пор для борьбы с плесневыми грибками употреблялись и традиционные средства, эффективность которых время от времени может превосходить новомодные препараты. Рассмотрим более известные и действующие традиционные средства:
1.Своими фунгицидными качествами с давних пор славится креозот, употребляющийся для обработки поверхностей, пораженных грибком и плесенью;
2. Кроме этого, для эффективной борьбы с плесенью используются следующие смеси, какие в 10 литрах воды содержат следующие составляющие:
- 2 литра уксусной эссенции и 500 г бронзового купороса против плесени;
- 1,5 кг фторида натрия, 500 г бронзового купороса и столько же железного купороса;
- 900 г бура, четыреста г борной кислоты и 1, четыре л 6 % уксуса.
Перед применением смеси обозначенных составов необходимо подогреть до 60-70 градусов, по окончании чего, применяя валик или кисть, нанести на пораженный участок и оставить до окончательного просыхания. Обработку необходимо повторить через месяц.

3.Для обработки кирпичных стенок не считая этого есть народные методы, подразумевающие применение:
- Промышленной 70 %-ной перекиси водорода;
- Соды, разведенной до кашицеобразного состояния;
- Консистенции пищевого уксуса с водой;
- Смесь мед спирта и глицерина в соотношении один : 1;
- Щелочи или хлорки.






